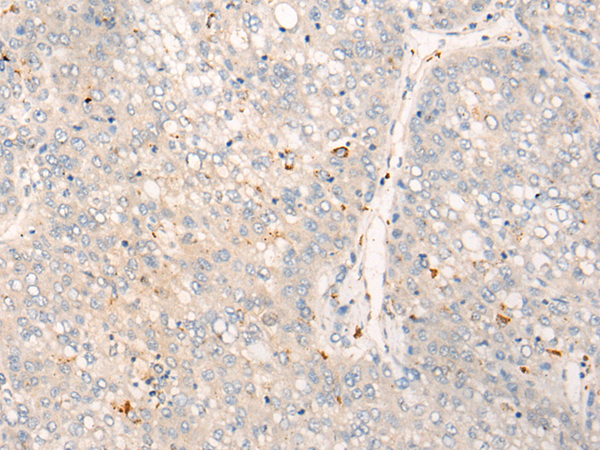

中文名稱: 兔抗ALK多克隆抗體
英文名稱: Anti-ALK rabbit polyclonal antibody
別 名: CD246; NBLST3
抗 原: ALK
儲 存: 冷凍(-20℃)
宿 主: Rabbit
反應(yīng)種屬: Human
相關(guān)類別: 一抗
克隆類型: rabbit polyclonal
技術(shù)規(guī)格
|
Background: |
This gene encodes a receptor tyrosine kinase, which belongs to the insulin receptor superfamily. This protein comprises an extracellular domain, an hydrophobic stretch corresponding to a single pass transmembrane region, and an intracellular kinase domain. It plays an important role in the development of the brain and exerts its effects on specific neurons in the nervous system. This gene has been found to be rearranged, mutated, or amplified in a series of tumours including anaplastic large cell lymphomas, neuroblastoma, and non-small cell lung cancer. The chromosomal rearrangements are the most common genetic alterations in this gene, which result in creation of multiple fusion genes in tumourigenesis, including ALK (chromosome 2)/EML4 (chromosome 2), ALK/RANBP2 (chromosome 2), ALK/ATIC (chromosome 2), ALK/TFG (chromosome 3), ALK/NPM1 (chromosome 5), ALK/SQSTM1 (chromosome 5), ALK/KIF5B (chromosome 10), ALK/CLTC (chromosome 17), ALK/TPM4 (chromosome 19), and ALK/MSN (chromosome X). |
|
Applications: |
ELISA, IHC |
|
Name of antibody: |
ALK |
|
Immunogen: |
Synthetic peptide of human ALK |
|
Full name: |
anaplastic lymphoma receptor tyrosine kinase |
|
Synonyms: |
CD246; NBLST3 |
|
SwissProt: |
Q9UM73 |
|
ELISA Recommended dilution: |
5000-10000 |
|
IHC positive control: |
Human liver cancer and human thyroid cancer |
|
IHC Recommend dilution: |
25-100 |

購物車
購物車 幫助
幫助
 021-54845833/15800441009
021-54845833/15800441009
